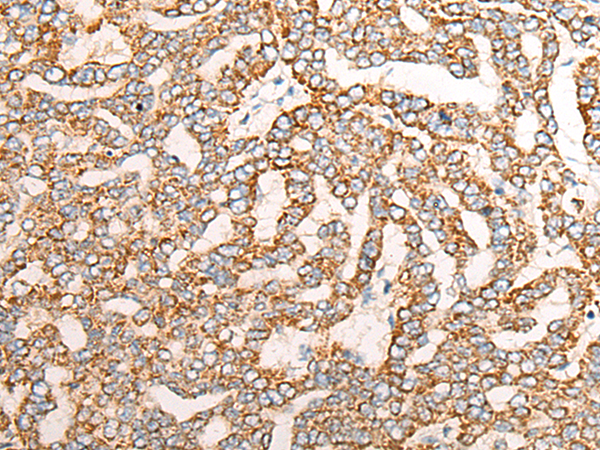

中文名稱: 兔抗NR0B2多克隆抗體
英文名稱: Anti-NR0B2 rabbit polyclonal antibody
別 名: nuclear receptor subfamily 0 group B member 2 SHP; SHP1
儲(chǔ) 存: 冷凍(-20℃)
抗 原: NR0B2’
宿 主: Rabbit
相關(guān)類別: 一抗
反應(yīng)種屬: Human, Mouse, Rat
標(biāo) 記 物: Unconjugate
克隆類型: rabbit polyclonal
技術(shù)規(guī)格
|
Background: |
The protein encoded by this gene is an unusual orphan receptor that contains a putative ligand-binding domain but lacks a conventional DNA-binding domain. The gene product is a member of the nuclear hormone receptor family, a group of transcription factors regulated by small hydrophobic hormones, a subset of which do not have known ligands and are referred to as orphan nuclear receptors. The protein has been shown to interact with retinoid and thyroid hormone receptors, inhibiting their ligand-dependent transcriptional activation. In addition, interaction with estrogen receptors has been demonstrated, leading to inhibition of function. Studies suggest that the protein represses nuclear hormone receptor-mediated transactivation via two separate steps: competition with coactivators and the direct effects of its transcriptional repressor function. |
|
Applications: |
ELISA, IHC |
|
Name of antibody: |
NR0B2 |
|
Immunogen: |
Fusion protein of human NR0B2 |
|
Full name: |
nuclear receptor subfamily 0 group B member 2 |
|
Synonyms: |
SHP; SHP1 |
|
SwissProt: |
Q15466 |
|
ELISA Recommended dilution: |
1000-2000 |
|
IHC positive control: |
Human liver cancer; Human esophagus cancer |

購(gòu)物車
購(gòu)物車 幫助
幫助
 021-54845833/15800441009
021-54845833/15800441009
